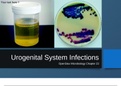
Latest Preview Thumbnail

OpenStax Microbiology
Latest uploads at OpenStax Microbiology. Looking for notes at OpenStax Microbiology? We have lots of notes, study guides and study notes available for your school.
-
878
- 0
-
44
All courses for OpenStax Microbiology
-
OPENSTAX MICROBIOLOGY 3
-
OpenStax Microbiology 873
-
Openstax microbiology 1
-
OPENSTAX-MICROBIOLOGY 2
Latest content OpenStax Microbiology

OpenStax Microbiology Test Bank Chapter 22: Respiratory System Infections * = Correct answer Multiple Choice 1. Which passageway connects the nasopharynx to the middle ear? A. eustachian tube* B. nasal cavity C. oropharynx D. sinus cavity Difficulty: Easy ASM Standard: N/A 2. Which described the palatine tonsils? A. connective and muscular tissue within the nasopharynx B. connective and muscular tissue within the oropharynx C. lymphoid tissue within the nasopharynx D. lymphoid ...
- Exam (elaborations)
- • 20 pages's •
-
OpenStax Microbiology•OpenStax Microbiology
Preview 3 out of 20 pages
Getting your document ready...
OpenStax Microbiology Test Bank Chapter 22: Respiratory System Infections * = Correct answer Multiple Choice 1. Which passageway connects the nasopharynx to the middle ear? A. eustachian tube* B. nasal cavity C. oropharynx D. sinus cavity Difficulty: Easy ASM Standard: N/A 2. Which described the palatine tonsils? A. connective and muscular tissue within the nasopharynx B. connective and muscular tissue within the oropharynx C. lymphoid tissue within the nasopharynx D. lymphoid ...

OpenStax Microbiology Test Bank Chapter 4: Prokaryotic Diversity * = Correct answer Multiple Choice 1. Which is the best example of a population? A. all the microbes living in a particular area B. all the microbes of a particular domain living in a particular area C. all the microbes of a single species living in a particular area* D. all the microbes living within the same host Difficulty: Moderate ASM Standard: 20 2. Microbial ecology is defined as the study of which of the follo...
- Exam (elaborations)
- • 18 pages's •
-
OpenStax Microbiology•OpenStax Microbiology
Preview 3 out of 18 pages
Getting your document ready...
OpenStax Microbiology Test Bank Chapter 4: Prokaryotic Diversity * = Correct answer Multiple Choice 1. Which is the best example of a population? A. all the microbes living in a particular area B. all the microbes of a particular domain living in a particular area C. all the microbes of a single species living in a particular area* D. all the microbes living within the same host Difficulty: Moderate ASM Standard: 20 2. Microbial ecology is defined as the study of which of the follo...

OpenStax Microbiology Test Bank- Chapter 01: An Invisible World OpenStax Microbiology Test Bank Chapter 1: An Invisible World Chapter 1: An Invisible World * = Correct answer Multiple Choice 1. Which of the following is true of the microbial world? A. All microbes are harmful.
- Exam (elaborations)
- • 18 pages's •
-
OpenStax Microbiology•OpenStax Microbiology
Preview 3 out of 18 pages
Getting your document ready...
OpenStax Microbiology Test Bank- Chapter 01: An Invisible World OpenStax Microbiology Test Bank Chapter 1: An Invisible World Chapter 1: An Invisible World * = Correct answer Multiple Choice 1. Which of the following is true of the microbial world? A. All microbes are harmful.

OpenStax Microbiology Test Bank Chapter 11: Mechanisms of Microbial Genetics * = Correct answer Multiple Choice 1. Gene expression includes which of the following? A. DNA replication B. replication, transcription, and translation C. transcription and translation* D. translation only Difficulty: Easy ASM Standard: N/A 2. The central dogma describes which of the following? A. the process by which enzymes are modified after translation B. the steps of gene expression* C. the way ...
- Exam (elaborations)
- • 37 pages's •
-
OpenStax Microbiology•OpenStax Microbiology
Preview 4 out of 37 pages
Getting your document ready...
OpenStax Microbiology Test Bank Chapter 11: Mechanisms of Microbial Genetics * = Correct answer Multiple Choice 1. Gene expression includes which of the following? A. DNA replication B. replication, transcription, and translation C. transcription and translation* D. translation only Difficulty: Easy ASM Standard: N/A 2. The central dogma describes which of the following? A. the process by which enzymes are modified after translation B. the steps of gene expression* C. the way ...

OpenStax Microbiology Test Bank- Chapter 01: An Invisible World OpenStax Microbiology Test Bank Chapter 1: An Invisible World Chapter 1: An Invisible World * = Correct answer Multiple Choice 1. Which of the following is true of the microbial world? A. All microbes are harmful. B. Humans could survive without microbes. C. Many microbes are helpful.* D. Most microbes are pathogenic. Difficulty: Easy ASM Standard: 23, 24 2. Which of the following is when humans first suspected th...
- Exam (elaborations)
- • 18 pages's •
-
OpenStax Microbiology•OpenStax Microbiology
Preview 3 out of 18 pages
Getting your document ready...
OpenStax Microbiology Test Bank- Chapter 01: An Invisible World OpenStax Microbiology Test Bank Chapter 1: An Invisible World Chapter 1: An Invisible World * = Correct answer Multiple Choice 1. Which of the following is true of the microbial world? A. All microbes are harmful. B. Humans could survive without microbes. C. Many microbes are helpful.* D. Most microbes are pathogenic. Difficulty: Easy ASM Standard: 23, 24 2. Which of the following is when humans first suspected th...

OpenStax Microbiology Test Bank Chapter 26: Nervous System Infections
- Package deal
- Exam (elaborations)
- • 17 pages's •
-
OpenStax Microbiology•OpenStax Microbiology
-
OpenStax Microbiology Test Bank Chapters (CHAPTER 1-26) UPDATED AUGUST 2021• ByElonMusk
Preview 3 out of 17 pages
Getting your document ready...
OpenStax Microbiology Test Bank Chapter 26: Nervous System Infections
OpenStax Microbiology Chapter 23 Urogenital System Infections
- Exam (elaborations)
- • 31 pages's •
-
OpenStax Microbiology•OpenStax Microbiology
Preview 4 out of 31 pages
Getting your document ready...
OpenStax Microbiology Chapter 23 Urogenital System Infections

OpenStax Microbiology Test Bank Chapter 12: Modern Applications of Microbial Genetics
- Package deal
- Exam (elaborations)
- • 17 pages's •
-
OpenStax Microbiology•OpenStax Microbiology
-
OpenStax Microbiology Test Bank Chapters (CHAPTER 1-26) UPDATED AUGUST 2021• ByElonMusk
Preview 3 out of 17 pages
Getting your document ready...
OpenStax Microbiology Test Bank Chapter 12: Modern Applications of Microbial Genetics

OpenStax Microbiology Test Bank Chapter 10: Biochemistry of the Genome
- Package deal
- Exam (elaborations)
- • 16 pages's •
-
OpenStax Microbiology•OpenStax Microbiology
-
OpenStax Microbiology Test Bank Chapters (CHAPTER 1-26) UPDATED AUGUST 2021• ByElonMusk
Preview 3 out of 16 pages
Getting your document ready...
OpenStax Microbiology Test Bank Chapter 10: Biochemistry of the Genome

OpenStax Microbiology Test Bank Chapter 8: Microbial Metabolism
- Package deal
- Exam (elaborations)
- • 16 pages's •
-
OpenStax Microbiology•OpenStax Microbiology
-
OpenStax Microbiology Test Bank Chapters (CHAPTER 1-26) UPDATED AUGUST 2021• ByElonMusk
Preview 3 out of 16 pages
Getting your document ready...
OpenStax Microbiology Test Bank Chapter 8: Microbial Metabolism
